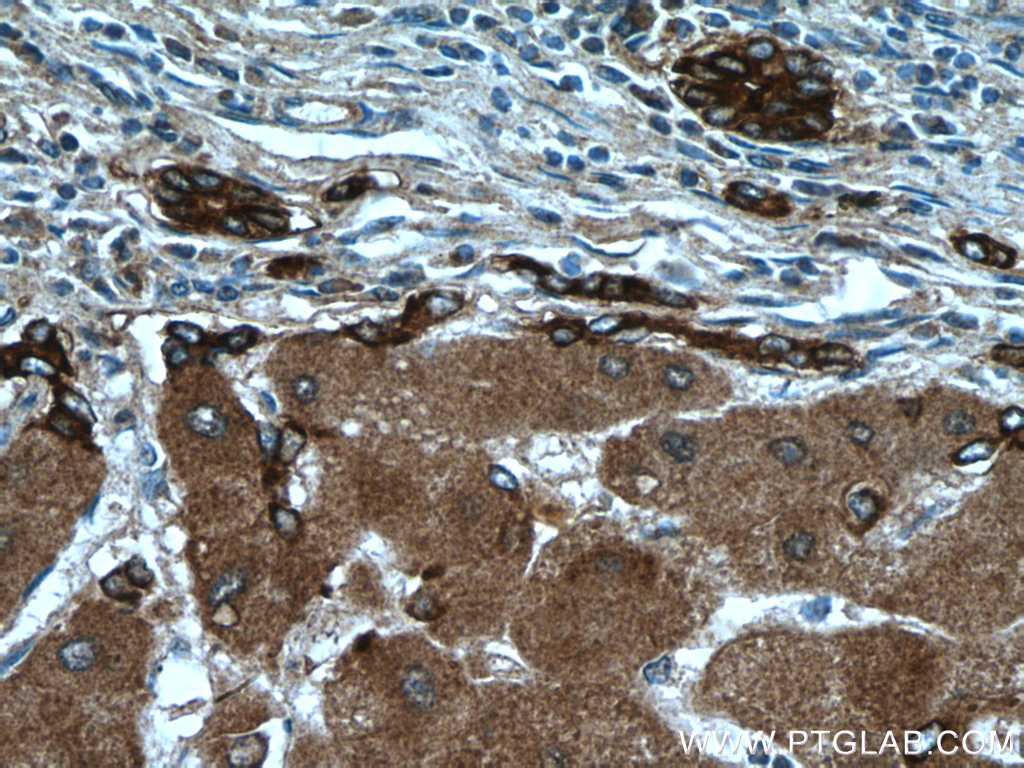

验证数据展示
经过测试的应用
| Positive WB detected in | human blood tissue, mouse brain tissue, human plasma tissue |
| Positive IHC detected in | human tonsillitis tissue, human colon tissue, human hepatocirrhosis tissue Note: suggested antigen retrieval with TE buffer pH 9.0; (*) Alternatively, antigen retrieval may be performed with citrate buffer pH 6.0 |
推荐稀释比
| 应用 | 推荐稀释比 |
|---|---|
| Western Blot (WB) | WB : 1:500-1:2000 |
| Immunohistochemistry (IHC) | IHC : 1:400-1:1600 |
| It is recommended that this reagent should be titrated in each testing system to obtain optimal results. | |
| Sample-dependent, Check data in validation data gallery. | |
产品信息
21131-1-AP targets Ceruloplasmin in WB, IHC, IF, ELISA applications and shows reactivity with human, mouse samples.
| 经测试应用 | WB, IHC, ELISA Application Description |
| 文献引用应用 | WB, IHC, IF |
| 经测试反应性 | human, mouse |
| 文献引用反应性 | human, mouse, chicken |
| 免疫原 |
CatNo: Ag15535 Product name: Recombinant human CP protein Source: e coli.-derived, PGEX-4T Tag: GST Domain: 194-446 aa of BC146663 Sequence: IGPLIICKKDSLDKEKEKHIDREFVVMFSVVDENFSWYLEDNIKTYCSEPEKVDKDNEDFQESNRMYSVNGYTFGSLPGLSMCAEDRVKWYLFGMGNEVDVHAAFFHGQALTNKNYRIDTINLFPATLFDAYMVAQNPGEWMLSCQNLNHLKAGLQAFFQVQECNKSSSKDNIRGKHVRHYYIAAEEIIWNYAPSGIDIFTKENLTAPGSDSAVFFEQGTTRIGGSYKKLVYREYTDASFTNRKERGPEEEHL 种属同源性预测 |
| 宿主/亚型 | Rabbit / IgG |
| 抗体类别 | Polyclonal |
| 产品类型 | Antibody |
| 全称 | ceruloplasmin (ferroxidase) |
| 别名 | CP, CERU, Cuproxidase ceruloplasmin, EC:1.11.1.27, EC:1.11.1.9 |
| 计算分子量 | 1065 aa, 122 kDa |
| 观测分子量 | 130-140 kDa, 85 kDa |
| GenBank蛋白编号 | BC146663 |
| 基因名称 | Ceruloplasmin |
| Gene ID (NCBI) | 1356 |
| RRID | AB_2878815 |
| 偶联类型 | Unconjugated |
| 形式 | Liquid |
| 纯化方式 | Antigen affinity purification |
| UNIPROT ID | P00450 |
| 储存缓冲液 | PBS with 0.02% sodium azide and 50% glycerol, pH 7.3. |
| 储存条件 | Store at -20°C. Stable for one year after shipment. Aliquoting is unnecessary for -20oC storage. |
背景介绍
Ceruloplasmin (CP) is a serum glycoprotein synthesized by hepatocytes and functions as the major transport protein of copper in blood where it acts as ferrodoxidase and is required for iron transport of transferrin. The intact ceruloplasmin migrated around 130-140 kDa and some proteolytic cleaved fragments could also be observed.
实验方案
| Product Specific Protocols | |
|---|---|
| IHC protocol for Ceruloplasmin antibody 21131-1-AP | Download protocol |
| WB protocol for Ceruloplasmin antibody 21131-1-AP | Download protocol |
| Standard Protocols | |
|---|---|
| Click here to view our Standard Protocols |
发表文章
| Species | Application | Title |
|---|---|---|
Adv Sci (Weinh) ITM2B Truncation Promotes Migrasome Formation to Accelerate Renal Cell Carcinoma Growth | ||
Int J Biol Sci Novel LncRNA LINC02936 Suppresses Ferroptosis and Promotes Tumor Progression by Interacting with SIX1/CP Axis in Endometrial Cancer
| ||
Carcinogenesis Identification of HCAR1 as a ferroptosis-related biomarker of gastric cancer based on a novel ferroptosis-related prognostic model and in vitro experiments | ||
J Agric Food Chem Drp1 Aggravates Copper Nanoparticle-Induced ER-Phagy by Disturbing Mitochondria-Associated Membranes in Chicken Hepatocytes | ||
J Neuroinflammation Aberrant copper metabolism and hepatic inflammation cause neurological manifestations in a mouse model of Wilson's disease | ||
Toxicology Benzyl butyl phthalate promotes ferroptosis in Sertoli cells via disrupting ceruloplasmin-mediated iron balance |